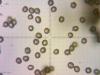
0606082011_t1.jpg
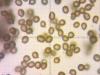
0506082011_t1.jpg

121

0606082011
Дата: 09.01.13
Добавлено: Tonya
Комментариев: 0
Просмотров: 1304
|
122

0506082011
Дата: 17.08.11
Добавлено: Tonya
Комментариев: 1
Просмотров: 1270
|
123

0506082011
Дата: 09.01.13
Добавлено: Tonya
Комментариев: 0
Просмотров: 1353
|
|
|
|
|
|
|
|
130

Дата: 10.12.15
Добавлено: Tonya
Комментариев: 0
Просмотров: 1269
|
131

1006082011
Дата: 17.08.11
Добавлено: Tonya
Комментариев: 0
Просмотров: 1247
|
132

1006082011
Дата: 17.08.11
Добавлено: Tonya
Комментариев: 0
Просмотров: 1266
|
133

17060811
Дата: 11.09.12
Добавлено: Tonya
Комментариев: 0
Просмотров: 1247
|
134

17060811
Дата: 11.09.12
Добавлено: Tonya
Комментариев: 0
Просмотров: 1259
|
135

1206082011
Дата: 17.08.11
Добавлено: Tonya
Комментариев: 0
Просмотров: 1205
|
136

1206082011
Дата: 17.08.11
Добавлено: Tonya
Комментариев: 0
Просмотров: 1230
|
137

1406082011
Дата: 17.08.11
Добавлено: Tonya
Комментариев: 0
Просмотров: 1222
|
138

1406082011
Дата: 17.08.11
Добавлено: Tonya
Комментариев: 0
Просмотров: 1193
|
139

1106082011
Дата: 17.08.11
Добавлено: Tonya
Комментариев: 0
Просмотров: 1244
|
140

1106082011
Дата: 17.08.11
Добавлено: Tonya
Комментариев: 0
Просмотров: 1198
|
141

1306082011
Дата: 17.08.11
Добавлено: Tonya
Комментариев: 0
Просмотров: 1274
|
142

1306082011
Дата: 17.08.11
Добавлено: Tonya
Комментариев: 0
Просмотров: 1172
|
143

1506082011
Дата: 17.08.11
Добавлено: Tonya
Комментариев: 0
Просмотров: 1235
|
144

1506082011
Дата: 17.08.11
Добавлено: Tonya
Комментариев: 0
Просмотров: 1211
|
145

Дата: 17.08.11
Добавлено: Tonya
Комментариев: 0
Просмотров: 1273
|
146

Дата: 17.08.11
Добавлено: Tonya
Комментариев: 0
Просмотров: 1246
|
|
|
|
|
151

0124092011
Дата: 25.09.11
Добавлено: Tonya
Комментариев: 0
Просмотров: 1293
|
152

0124092011
Дата: 25.09.11
Добавлено: Tonya
Комментариев: 0
Просмотров: 1201
|
|
|
|
|
|
157

0424092011
Дата: 25.09.11
Добавлено: Tonya
Комментариев: 0
Просмотров: 1215
|
158

0424092011
Дата: 25.09.11
Добавлено: Tonya
Комментариев: 0
Просмотров: 1123
|
159

0224092011
Дата: 25.09.11
Добавлено: Tonya
Комментариев: 0
Просмотров: 1256
|
160

0224092011
Дата: 25.09.11
Добавлено: Tonya
Комментариев: 0
Просмотров: 1239
|
















































 грибы
грибы фотогалерея
фотогалерея флора
флора фауна
фауна птицы
птицы млекопитающие
млекопитающие пресмыкающиеся
пресмыкающиеся земноводные
земноводные бабочки
бабочки насекомые
насекомые рыбы
рыбы видео
видео казахстан
казахстан кулинария
кулинария статьи
статьи ссылки
ссылки о нас
о нас